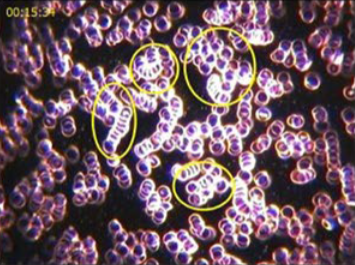

What is the Uniwave Instant Coffee Premix 5in1
What is the Uniwave Instant Coffee Premix 5in1  Blended especially with coffee beans of excellent quality and other healthy ingredients with no artificial coloring and preservations.
Blended especially with coffee beans of excellent quality and other healthy ingredients with no artificial coloring and preservations.
 You can enjoy pure coffee and absorb the excellent effects the healthy ingredients could bring to your health. It is also free of sugar and is therefore suitable for those who want to limit their sugar intake when consuming instant coffee.
You can enjoy pure coffee and absorb the excellent effects the healthy ingredients could bring to your health. It is also free of sugar and is therefore suitable for those who want to limit their sugar intake when consuming instant coffee.
 Reduces the risk of cancer
Reduces the risk of cancer Enhance the Immune System
Enhance the Immune System Improve cardiovascular health
Improve cardiovascular health Anti-inflammatory Properties
Anti-inflammatory Properties Has Antioxidant benefits
Has Antioxidant benefits Promotes weight Loss
Promotes weight Loss
Before using Uniwave Instant Coffee Premix 5in1 by Quantes Technology

30 minutes after using Uniwave Instant Coffee Premix 5in1 by Quantes Technology
Ceylon Cinnamon : A spice that fights cancer, and helps control blood pressure.
Black Pepper : A spice with no calories, its aids in weight loss, and is rich in antioxidants.
Turmeric : Known for its disease-fighting abilities, it supports liver health, and aids digestion.
FiberCreme : A diary alternative that's high in fiber and free from gluten, cholestrol, making it a healthy creamer option.
Robusta Coffee : A bitter, low-acidity coffee that promotes weight loss, and enhances brain function.
Arabica Coffee : A coffee variety that keeps you alert and hydrated, and helps maintain healthy skin.
It has 100,000 different kinds of decoding technologies. Boosting the immune system, enhance the metabolism, and recharge the body cells.
 Provide Optimum Energy for Healthy Lifestyle
Provide Optimum Energy for Healthy Lifestyle Supports Rejuventaion of Cells and Repair the Damaged Cells.
Supports Rejuventaion of Cells and Repair the Damaged Cells.  Trigger the Production of Stem Cells for New Cell Formation.
Trigger the Production of Stem Cells for New Cell Formation.